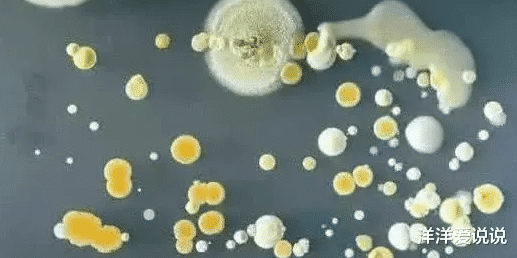
睡眠|央视曝光:比马桶还脏,是病毒的最佳载体,你却天天抱着吃饭

睡眠|央视曝光:比马桶还脏,是病毒的最佳载体,你却天天抱着吃饭

文章图片
文章图片

现在因为社会的发展越来越好 , 生活水平也变得更好了 , 现代人更追求健康 , 可以说现在人为了健康 , 比如跑步 , 健身等各种生活方式 , 以及吃很多补品 , 都是为了更健康的生活 , 但有一种很脏的东西 , 比马桶还脏 , 是病毒的最佳载体 , 你却天天抱着吃饭 。 你以为是什么吃的喝的?全不对 , 你生活中常常拿在手里的东西 , 原来是手机 。 你想到了吗?
央视的节目报道过 , 手机现在是人不可缺少的通讯和娱乐工具 , 但是手机上有无尽的细菌 , 很多人吃饭睡觉都抱着它 , 其实就是抱着细菌 , 你相信吗?其实道理很简单 。
当手机放在显微镜下 , 手机上的细菌数量太多了 , 专家研究:手机上的细菌十分复杂 , 因为很多人常年不清洗手机 , 最多就用纸巾擦一下 , 怎么可能不脏呢?
经过72小时的细菌培养 , 细菌马上长成了菌落 , 看上去你一片草原一样的茂盛 , 你想象你一边吃饭一边玩手机 , 是不是心中有点不舒服 , 很多人睡觉还把手机放在身上 , 真是要注意了 。
起码我们在睡觉吃饭的时候应该离手机远一点 , 这样才更健康 , 其余的比如电脑键盘等 , 也是比较脏的 , 大家要尽量保持清洁 。
【睡眠|央视曝光:比马桶还脏,是病毒的最佳载体,你却天天抱着吃饭】大家也不要担心 , 只要注意养成好习惯就可以了 , 很多生活习惯一定要注意 , 健康是第一位的吗 , 我们大家一定要爱护自己的身体 , 欢迎你踊跃发言 , 小编祝你健康幸福 。
推荐阅读
- 健养小王医师|不仅气色好了,睡眠也改善了,红枣与它是“天生一对”连食7天
- 睡眠|寿命短的男人,睡觉时会有四个信号,超过两个以上,提示该体检了
- 育儿张医师|健脾养胃补血,睡眠好了,肌肤更显年轻,煮小米粥时加一宝
- 健康科谱程医师|常吃以下食物,改善睡眠,皮肤光滑有弹性,女性想要抗衰老
- 盛唐即墨|朋友圈曝光透露背后原因,武汉一护士和护理主任争执后坠亡
- 牛奶|4种“假牛奶”已被央视拉黑,价高营养少,很多父母却成箱购买
- 健康王医师|3种食物坚持吃,补益气血,美白抗皱,安神助睡眠,夏天来了
- 睡眠|睡觉时有4个表现,是在提示:血管已\严重堵塞\!3个习惯要丢
- 医线天|4个危害不容忽视,记好睡前5不要,一夜好睡眠,经常失眠
- 健康睡眠研究院|做个爱笑的人!,大数据分析:乐观让人更长寿










![[刘国梁]刘国梁待人不公?20岁小将2次夺冠遭冷藏,郭跃式悲剧再上演](http://img88.010lm.com/img.php?https://image.uc.cn/s/wemedia/s/2020/2bf68c88a7b445d51abf428bd39d001e.jpg)




